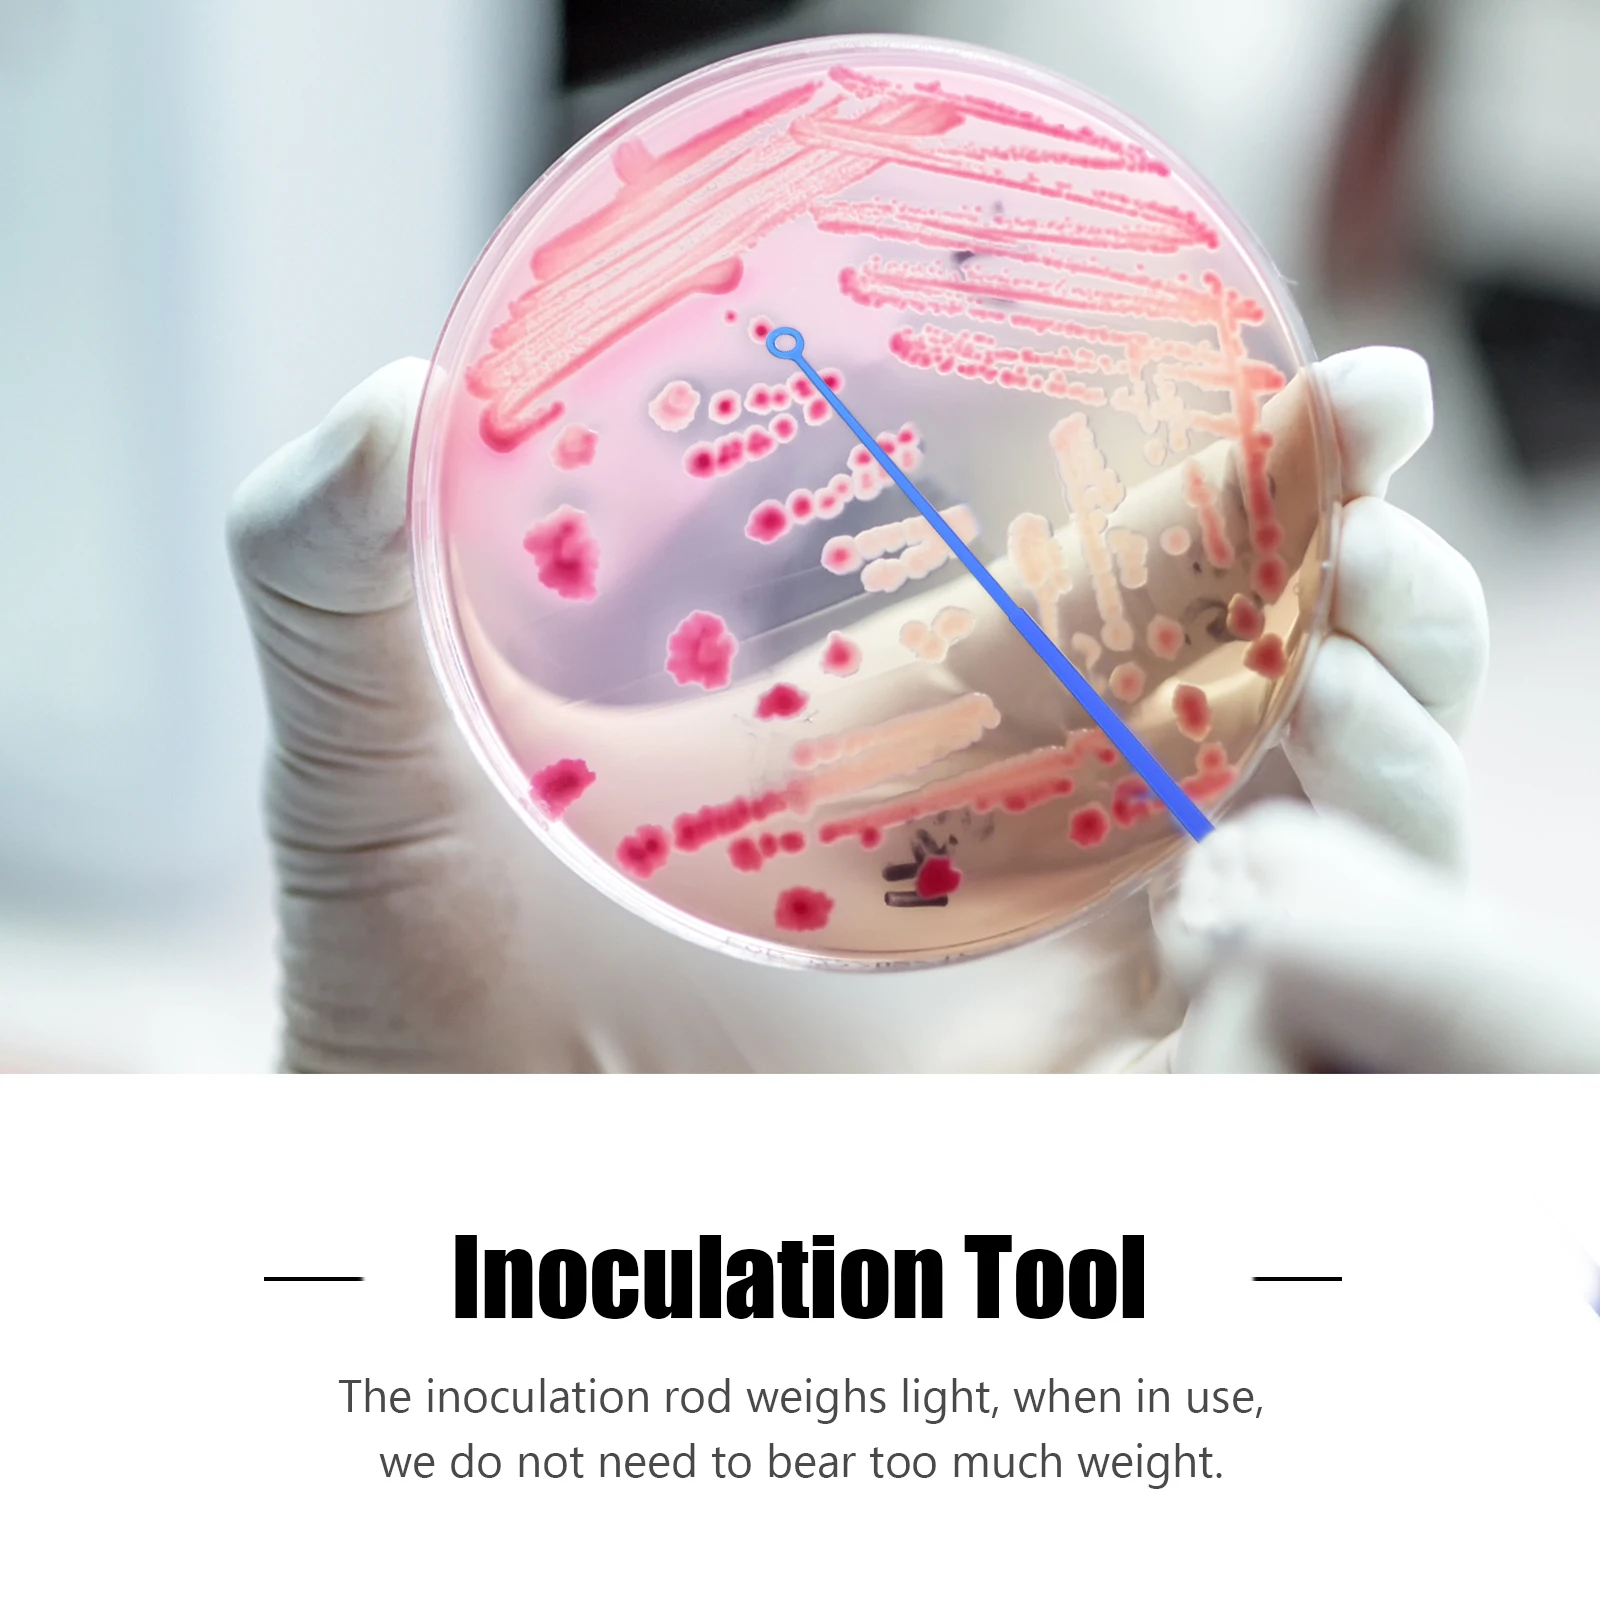
20 Pcs Inoculation Rods Microbiology Tools Heat Resistant Stable For Test Experiment Sample Transfer Petri Dish

Женское блестящее мини-платье с открытой спиной, однотонное Элегантное синее платье-трапеция на бретелях-спагетти для клувечерние, лето 2021













артикул: 1005004238570999
СОГЛАСНО НАШИМ ДАННЫМ, ЭТОТ ПРОДУКТ СЕЙЧАС НЕ ДОСТУПЕН
$10.12
Доставка из: Китай
График изменения цены & курс обмена валют
Пользователи также просматривали

$24.56
Women's Fashion Lab Coat Short Sleeve Doctor Nurse Dress Long Sleeve Medical Uniforms White Jacket With Adjustable Waist Belt
aliexpress.ru
$66.74
Light Luxury Modern Crystal Crane Decoration Home Living Room Wine Cabinet TV Cabinet Soft Outfit Decoration Decoration
aliexpress.ru
$16.18
Обои Liberty (вспененный винил на ф/о) Джаспер 0424-4 (рисунок 1-3) роз, 1,06х10,05м
tddomovoy.ru
$13.82
Щетка для швабры из козьей шерсти, цвет дерева, многоразовая, набор кистей для швабры, ручка для рисования акрилом
joom.ru
$5.02
Сердца Запястье Ювелирные Изделия Колокольчики Бусины Ювелирные изделия Подарок Мода Цепочка Браслет Женщины Мужчины
joom.ru
$3.05
Naruto Anime Phone Case For Samsung Galaxy A72 A52 A42 A32 A22 A21s A02s A12 A51 A71 A01 4th 7th Hokage Cloak Soft Silicone Case
aliexpress.ru
$7.35
Topdon Phoenix Elite auto car obd2 online programming coding battery tester full system active diagnostic scanner tools machine
alibaba.com
$1.70
BSCI Audit Factory Custom Durable Dog Chew Toys for Small and Medium Dogs with Bird Shape
alibaba.com
$14.16
Puffy Bubble Down Coats Jacket Winter Clothes for Women Winter Jackets Zipper Cropped Bubble Coat for Ladies Women Puff Jackets
alibaba.com
$3.00
Easyzlm Wholesale Dual Use Multifunctional Microblading Manual Tattoo Eyebrow Pen Holder, White/pink/gold/blue/black/silver
alibaba.com
$2.88
High Performance 7mm SBR Neoprene Sleeves Weightlifting Knee Compression Support for Cross Training Gym Workout, Powerlifting, Black
alibaba.com
$3.82
Custom logo 500ml vacuum insulated stainless steel keep hot termos hydro water thermos bottle thermoflask with flex lid, Customized color
alibaba.com
$17.50
Женский модный браслет из серебра S925 пробы, яркое серебряное Ювелирное Украшение со звездой, Прямая поставка
aliexpress.ru
$3.64
Adjustable Portable Aluminum Laptop Desk for Ergonomic TV Bed PC Table Stand Notebook Table Desk Stand With Mouse Pad 420*260 mm
aliexpress.ru
$3.03
Gay Men Underwear Sexy Erotic Homens Men Thong Sexy Underwear Mens Thongs And G Strings Jockstrap Gay Mens Thongs jockstrap
aliexpress.com
$0.39
W3230 DC 12V 24V 110V 220V AC Digital Temperature Controller LED Display Thermostat With Heating Cooling Switch NTC Sensor
aliexpress.com
$11.86
Spring autumn new style lovely girls slippers indoor floor home floor non-slip comfort fashion women slippers girl shoes
aliexpress.com
$18.89
Крепление для перил, стальной зажим для зонта, устойчивый к атмосферным воздействиям, прочная подставка для зонта, железный универсальный зажим для зонта, сад
aliexpress.ru
$1.17
20 Pcs Inoculation Rods Microbiology Tools Heat Resistant Stable For Test Experiment Sample Transfer Petri Dish
aliexpress.ru
$5.08
Zootopia 15 см плюшевая кукла-игрушка кулон Дисней Джуди Ник флэш леопард полицейский мягкий милый брелок автомобильная сумка кулон подарок
aliexpress.ru
$51.37
Backseat Bed For Car Folding Portable Car Bed Tailgate Accessories For Storage Napping Kids Family Outdoor Activity Tent Friends
aliexpress.com
$12.34
Запчасти для пылесоса для Q6/Q7/Q8/WQ61/WQ71/WQ81/W3N5, эмиссионный фильтр, тонкий пылевой фильтр, запасные сменные аксессуары
aliexpress.ru
$4.70
Светодиодные чайные свечи, беспламенные светодиодные мерцающие электрические свечи, украшения, день рождения, праздник, романтическая свадьба
aliexpress.ru








